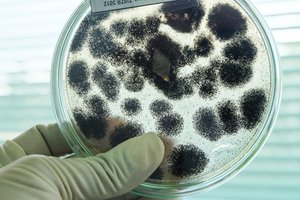
Medikai sunerimę: po ilgos pertraukos diagnozuotas buboninis maras

Per mėnesį visiems suaugusiems asmenims, kuriems nustatytas sunkus šlapimo nelaikymas, bus kompensuojami 45 vienetai sauskelnių, o asmenims, kuriems nustatytas vidutinis šlapimo nelaikymas – 60 vienetų įklotų. Vaikams, kuriems nustatyta visiška negalia (ar sunkaus neįgalumo lygis), kaip ir anksčiau, per mėnesį bus kompensuojama 60 vienetų sauskelnių arba 60 vienetų įklotų.
Nelaikantiems išmatų tiek vaikams, tiek suaugusiems bus kompensuojama 45 vienetai sauskelnių arba 60 vienetų įklotų per mėnesį.
Taip pat, jei asmeniui nustatytas ir šlapimo, ir išmatų nelaikymas, jam būtų sudaryta galimybė gauti kompensuojamąsias sauskelnes dėl abiejų diagnozių atskirai, t. y. gauti 90 vienetų sauskelnių per mėnesį (šiuo metu leidžiama išrašyti 30/45 vnt. sauskelnių per mėnesį nustačius arba vieną arba dvi diagnozes vienu metu).
Iki šiol kompensuojamųjų sauskelnių, įklotų ar vienkartinių paklodžių gydytojai, slaugytojai galėjo išrašyti šlapimo arba išmatų nelaikantiems žmonėms, kuriems nustatyta visiška negalia ar specialusis nuolatinės slaugos poreikis.
Susiję straipsniai
Taip pat šios priemonės buvo skiriamos žmonėms, kuriems diagnozuota galvos ir nugaros smegenų displazija, galvos ir nugaros smegenų kraujotakos sutrikimai, dėl centrinės nervų sistemos ir nugaros smegenų sužalojimo padarinių, liekamųjų kūdikių cerebrinio paralyžiaus reiškinių, sergant išsėtine skleroze.
Taip pat nuo šiol vaikams, kurie netoleruoja laktozės, bus kompensuojama daugiau specialios paskirties maisto produktų – buvo praplėstas indikacijų sąrašas, pagal kurį gali būti skiriami specialios paskirties maisto produktai.
Primename, kad tiek kompensuojamųjų sauskelnių, tiek kitų kompensuojamųjų medicinos pagalbos priemonių, naudojamų turint šlapimo ir išmatų nelaikymo problemų, receptus gali išrašyti ne tik gydytojai, bet ir slaugytojai, jei tai jau pakartotinis recepto išrašymas ir gydytojas yra nustatęs šlapimo nelaikymo laipsnį.
PSDF biudžeto lėšomis kompensuojamos tik tos medicinos pagalbos priemonės, kurios yra įrašytos į Kompensuojamųjų medicinos pagalbos priemonių sąrašą (jį galite rasti čia). Pernai šioms priemonėms iš PSDF biudžeto buvo išleista 15,3 mln. eurų. Jas naudojo 147,6 tūkst. žmonių.